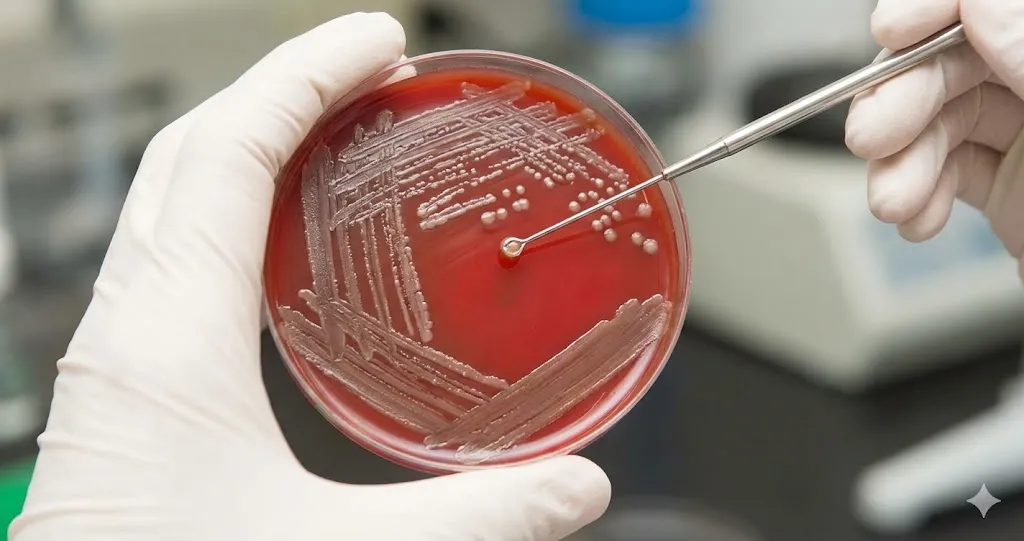
میکروبیولوژی 2

کارآموزی میکروبیولوژی در آزمایشگاه | بازار کار میکروبرولوژی

دنیای موجودات ذرهبینی، دنیایی شگفتانگیز و در عین حال پیچیده است. دانشجویان رشتههای زیستشناسی و علوم آزمایشگاهی، سالها در کلاسهای درس با مفاهیم تئوری باکتریها، ویروسها و قارچها آشنا میشوند. اما زمانی که نوبت به تشخیص و کار عملی میرسد، تنها یک کارآموزی میکروبیولوژی است که میتواند دانشجو را به یک کارشناس ماهر تبدیل کند. فاصله بین آنچه در کتابها میخوانیم و آنچه زیر میکروسکوپ در یک نمونه واقعی بیمار میبینیم، بسیار زیاد است. این دوره، پلی حیاتی برای ورود به بازار کار و درک واقعیتهای یک آزمایشگاه تشخیصی یا تحقیقاتی محسوب میشود.
اهمیت حیاتی کارآموزی میکروبیولوژی
چرا باید حتماً در یک دوره کارآموزی میکروبیولوژی شرکت کنیم؟ پاسخ ساده است: مهارت دست. در دانشگاه، معمولاً آزمایشها روی نمونههای استاندارد و باکتریهای شناختهشده انجام میشود. اما در محیط واقعی، شما با نمونههای عفونی، آلوده و ناشناخته سروکار دارید. یک کارآموزی میکروبیولوژی استاندارد به شما میآموزد که چگونه بدون به خطر انداختن جان خود و همکارانتان، عامل بیماریزا را از میان انبوهی از سلولها و آلودگیها تشخیص دهید.
علاوه بر این، کارفرمایان امروزی به دنبال مدرک تحصیلی صرف نیستند. آنها به دنبال فردی هستند که بتواند پشت هود آزمایشگاهی بنشیند و بدون لرزش دست، کشت خطی بدهد. گذراندن یک دوره کارآموزی میکروبیولوژی نشاندهنده علاقه و آمادگی شما برای رویارویی با چالشهای واقعی محیط کار است.

پیشنیازهای ورود به بخش میکروبشناسی
قبل از اینکه روپوش سفید خود را بپوشید و وارد بخش کارآموزی میکروبیولوژی شوید، باید ذهنی آماده داشته باشید. مرور جزوات باکتریشناسی عمومی و سیستماتیک بسیار کمککننده است. شما باید تفاوت باکتریهای گرم مثبت و گرم منفی، شکلهای مختلف آنها (کوکسیها و باسیلها) و محیطهای کشت پایه را بشناسید.
در روزهای اول کارآموزی میکروبیولوژی، معمولاً مسئول بخش شما را با قوانین ایمنی آشنا میکند. اما داشتن اطلاعات قبلی درباره خطرات زیستی، شما را یک قدم جلوتر نگه میدارد. به یاد داشته باشید که در این بخش، با جان موجودات زنده (باکتریها) و جان بیماران سروکار دارید، پس دقت حرف اول را میزند.
ایمنی و حفاظت؛ اولین درس کارآموزی
اولین و مهمترین چیزی که در کارآموزی میکروبیولوژی یاد میگیرید، نحوه محافظت از خودتان است. شما با نمونههای ادرار، مدفوع، خلط و زخم سروکار دارید که ممکن است حاوی خطرناکترین پاتوژنها باشند.
استفاده صحیح از دستکش، ماسک و عینک محافظ، و همچنین نحوه صحیح شستشوی دستها پس از هر بار تماس با نمونه، از اصول اولیه است. همچنین در طول کارآموزی میکروبیولوژی یاد میگیرید که چگونه زبالههای عفونی را از زبالههای معمولی تفکیک کنید و با نحوه کار دستگاه اتوکلاو (دستگاه استریلکننده با بخار) برای بیخطرسازی پسماندها آشنا میشوید. عدم رعایت این نکات میتواند باعث انتقال عفونت به خارج از آزمایشگاه شود.
بخشبندیهای مختلف در دوره کارآموزی
یک آزمایشگاه میکروبشناسی معمولاً به چند بخش تقسیم میشود که در طول کارآموزی میکروبیولوژی در همه آنها چرخش خواهید داشت:
۱. پذیرش و نمونهگیری
شاید تصور کنید کار شما فقط با میکروسکوپ است، اما یک کارآموز باید بداند نمونه چگونه پذیرش میشود. آیا ظرف نمونه استریل بوده؟ آیا حجم نمونه کافی است؟ در کارآموزی میکروبیولوژی میآموزید که اگر نمونهای شرایط استاندارد را نداشته باشد (مثلاً نمونه ادراری که ساعتها بیرون مانده)، نتایج کشت کاملاً غلط خواهد بود و باید نمونه را رد کنید.
۲. بخش محیطسازی
قلب تپنده بخش میکروب، محیطهای کشت هستند. در کارآموزی میکروبیولوژی، شما یاد میگیرید چگونه محیطهای کشت مختلف مثل “بلاد آگار”، “مکانکی” و “ایامبی” را بسازید. وزن کردن پودرها، حل کردن آنها در آب مقطر، تنظیم اسیدیته و در نهایت استریل کردن آنها با اتوکلاو، پروسهای دقیق است که هر کارآموزی باید تجربه کند. اگر محیط کشت آلوده باشد، تمام زحمات بخش تشخیص به هدر میرود.
۳. رنگآمیزیهای تشخیصی
یکی از جذابترین بخشهای کارآموزی میکروبیولوژی، رنگآمیزی لامهاست. رنگآمیزی “گرم” (Gram) نان شب یک میکروبیولوژیست است. شما یاد میگیرید چگونه از نمونه اسمیر تهیه کنید، آن را روی لام تثبیت کنید و مراحل رنگآمیزی کریستال ویوله، لوگول، الکل-استون و سافرانین را انجام دهید. تشخیص اینکه باکتری زیر میکروسکوپ بنفش (گرم مثبت) است یا صورتی (گرم منفی)، مسیر تشخیص را کاملاً تغییر میدهد. همچنین رنگآمیزیهای تخصصیتر مثل “زیل-نلسون” برای تشخیص باکتری سل نیز در مراحل پیشرفتهتر کارآموزی میکروبیولوژی آموزش داده میشود.
۴. کشت و ایزولاسیون
هنر یک میکروبیولوژیست در نحوه کشت دادن اوست. در کارآموزی میکروبیولوژی، ساعتها تمرین میکنید تا بتوانید با “لوپ” (ابزار کشت)، باکتریها را طوری روی محیط جامد پخش کنید که “تککلونی” (تجمع خالص باکتریها) ایجاد شود. این تککلونیها برای تستهای بعدی حیاتی هستند. تکنیکهای کشت چهار مرحلهای و چمنی از مهارتهایی است که باید ملکه ذهن شما شود.
تستهای بیوشیمیایی و آنتیبیوگرام
پس از اینکه باکتری رشد کرد، نوبت به شناسایی هویت آن میرسد. در طول کارآموزی میکروبیولوژی، شما با مجموعهای از تستهای بیوشیمیایی آشنا میشوید. تستهایی مثل کاتالاز (برای تمایز استافیلوکوک از استرپتوکوک)، کوagulase، اکسیداز و محیطهای قندی افتراقی. هر تغییر رنگ در لولههای آزمایش، یک کد رمز است که شما باید آن را رمزگشایی کنید تا به نام باکتری برسید.
پس از تشخیص باکتری، پزشک نیاز دارد بداند چه دارویی روی آن موثر است. اینجا تست “آنتیبیوگرام” وارد میشود. در کارآموزی میکروبیولوژی یاد میگیرید که دیسکهای آنتیبیوتیک را با فواصل منظم روی کشت چمنی باکتری قرار دهید. روز بعد، با خطکش قطر هاله عدم رشد را اندازه میگیرید. این بخش بسیار حساس است، زیرا گزارش اشتباه شما میتواند باعث شود بیمار دارویی مصرف کند که هیچ تاثیری بر بیماریاش ندارد.
بخش آنالیز ادرار و انگلشناسی
اگرچه گاهی این بخشها جدا هستند، اما در بسیاری از آزمایشگاهها، کارآموزی میکروبیولوژی شامل بخش آنالیز ادرار و مدفوع هم میشود. در آنالیز ادرار، شما با بررسی نوار ادرار و سپس دیدن رسوب ادرار زیر میکروسکوپ، سلولهای خونی، باکتریها، کریستالها و سیلندرها را شناسایی میکنید. تشخیص تفاوت بین گلبول سفید و سلول اپیتلیال، مهارتی است که فقط با دیدن هزاران نمونه در کارآموزی میکروبیولوژی به دست میآید.
در بخش مدفوع نیز، جستجو برای انگلها، کیستها و تخم کرمها انجام میشود. این بخش نیاز به دقت بینایی بالا و صبر زیاد دارد، چرا که آلودگیهای مدفوعی زیاد است و پیدا کردن یک انگل در میان آنها دشوار است.
بیشتر بخوانید : میکروبیولوژی دارویی: اصول کلیدی، کاربردها و چالشها
چالشهای دوران کارآموزی
نباید انتظار داشته باشید که کارآموزی میکروبیولوژی همیشه تمیز و خوشبو باشد. بوی نامطبوع محیطهای کشت میکروبی، کار با نمونههای آلوده و ایستادنهای طولانیمدت از سختیهای این دوره است. همچنین، خطر آلودگی همیشه در کمین است. یک کارآموز موفق کسی است که بر این سختیها غلبه کند و تمرکز خود را بر یادگیری بگذارد.
یکی دیگر از چالشها، حجم کاری بالاست. در روزهای شلوغ، ممکن است صدها نمونه وارد بخش شود. مدیریت زمان و اولویتبندی کارها مهارتی است که به مرور در کارآموزی میکروبیولوژی کسب خواهید کرد. شما یاد میگیرید که نمونههای مایع نخاعی یا خون اورژانسی هستند و باید قبل از سایر نمونهها پردازش شوند.
مهارتهای نرم در کنار مهارتهای فنی
علاوه بر کار با میکروسکوپ، کارآموزی میکروبیولوژی به شما کار تیمی را میآموزد. آزمایشگاه یک سیستم به هم پیوسته است. اشتباه در بخش نمونهگیری، کار بخش میکروب را خراب میکند و اشتباه بخش میکروب، پزشک را گمراه میسازد. ارتباط موثر با همکاران، مسئولیتپذیری، دقت در ثبت نتایج و رازداری درباره اطلاعات بیماران، از جمله اخلاق حرفهای است که در محیط واقعی کار نهادینه میشود.

آینده شغلی پس از کارآموزی
گذراندن موفقیتآمیز یک دوره کارآموزی میکروبیولوژی، رزومه شما را بسیار سنگین میکند. وقتی برای استخدام به آزمایشگاههای پاتوبیولوژی، بیمارستانها، کارخانههای داروسازی یا صنایع غذایی مراجعه میکنید، داشتن تجربه عملی برگ برنده شماست. کارفرما با دیدن گواهی کارآموزی میکروبیولوژی متوجه میشود که شما با فضای کار آشنا هستید، ترس از نمونه ندارید و نیاز به آموزشهای اولیه زمانبر نخواهید داشت. حتی اگر قصد ادامه تحصیل در مقاطع بالاتر را داشته باشید، دید عملی که در این دوره کسب کردهاید، به درک بهتر مقالات و انجام پایاننامههای تحقیقاتی کمک شایانی میکند.
جمعبندی
دوره کارآموزی میکروبیولوژی یک سفر هیجانانگیز از دنیای کتابها به دنیای واقعیتهای سلولی است. جایی که شما به عنوان یک کارآگاه زیستی، عوامل بیماریزا را شناسایی میکنید و در روند درمان بیماران نقش مستقیم دارید. اگرچه این مسیر با بوهای نامطبوع و خطرات احتمالی همراه است، اما لذت دیدن اولین لام گرم که خودتان رنگ کردهاید یا تشخیص صحیح یک باکتری نادر، خستگی را از تن بیرون میکند.
اگر دانشجوی زیستشناسی یا علوم آزمایشگاهی هستید، لحظهای در شروع کارآموزی میکروبیولوژی تردید نکنید. این دوره سرمایهگذاری روی آینده شغلی و حرفهای شماست که مهارتهایی ماندگار را به شما هدیه میدهد.

